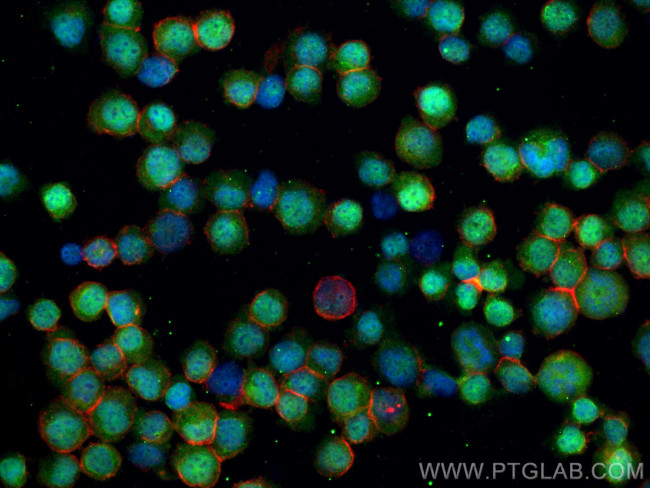
WT1 Antibody in Immunocytochemistry (ICC/IF)

Search
Proteintech
WT1 Polyclonal Antibody
{{$productOrderCtrl.translations['antibody.pdp.commerceCard.promotion.promotions']}}
{{$productOrderCtrl.translations['antibody.pdp.commerceCard.promotion.viewpromo']}}
{{$productOrderCtrl.translations['antibody.pdp.commerceCard.promotion.promocode']}}: {{promo.promoCode}} {{promo.promoTitle}} {{promo.promoDescription}}. {{$productOrderCtrl.translations['antibody.pdp.commerceCard.promotion.learnmore']}}
产品信息
12609-1-AP
种属反应
已发表种属
宿主/亚型
分类
类型
抗原
偶联物
形式
浓度
规格
纯化类型
保存液
内含物
保存条件
运输条件
产品详细信息
Immunogen sequence: MEKGYSTVT FDGTPSYGHT PSHHAAQFPN HSFKHEDPMG QQGSLGEQQY SVPPPVYGCH TPTDSCTGSQ ALLLRTPYSS DNLYQMTSQL ECMTWNQMNL GATLKGVAAG SSSSVKWTEG QSNHSTGYES DNHTTPILCG AQYRMHTHGV FRGIQDVRRV PGVAPTLVRS ASETSEKRPF MCAYPGCNKR YFKLSHLQMH SRKHTGEKPY QCDFKDCERR FSRSDQLKRH QRRHTGVKPF QCKTCQRKFS RSDHLKTHTR THTGEKPFSC RWPSCQKKFA RSDELVRHHN MHQRNMTKLQ LAL (1-302 aa encoded by BC032861)
靶标信息
The Wilms Tumor 1 gene encodes one of the WPP domain-interacting proteins (Wilms Tumor 1/AT5G11390, WIT2/AT1G68910) required for RanGAP nuclear envelope association in root tip cells. Ran GTPase plays essential roles in multiple cellular processes, including nucleocytoplasmic transport, spindle formation, and postmitotic nuclear envelope reassembly. The cytoplasmic Ran GTPase activating protein RanGAP is critical to establish a functional RanGTP/RanGDP gradient across the nuclear envelope and is associated with the outer surface of the nuclear envelope in metazoan and higher plant cells. Arabidopsis thaliana RanGAP association with the root tip nuclear envelope requires a family of likely plant-specific nucleoporins combining coiled-coil and transmembrane domains (CC-TMD) and WPP domain-interacting proteins (WIPs). Wilms Tumor 1 and WIT2 have been identified as a second family of CC-TMD proteins, structurally similar, yet clearly distinct from the WIP family, that is required for RanGAP nuclear envelop association in root tip cells.
仅用于科研。不用于诊断过程。未经明确授权不得转售。
生物信息学
蛋白别名: Ewing sarcoma-Wilms tumor gene fusion; unnamed protein product; Wilms tumor 1; Wilms tumor protein; Wilms tumor protein homolog; Wilms' tumor protein; WT; WT33
基因别名: AWT1; D630046I19Rik; GUD; NPHS4; WAGR; WIT-2; WT-1; WT1; WT33
UniProt ID: (Human) P19544, (Rat) P49952
Entrez Gene ID: (Human) 7490, (Mouse) 22431, (Rat) 24883